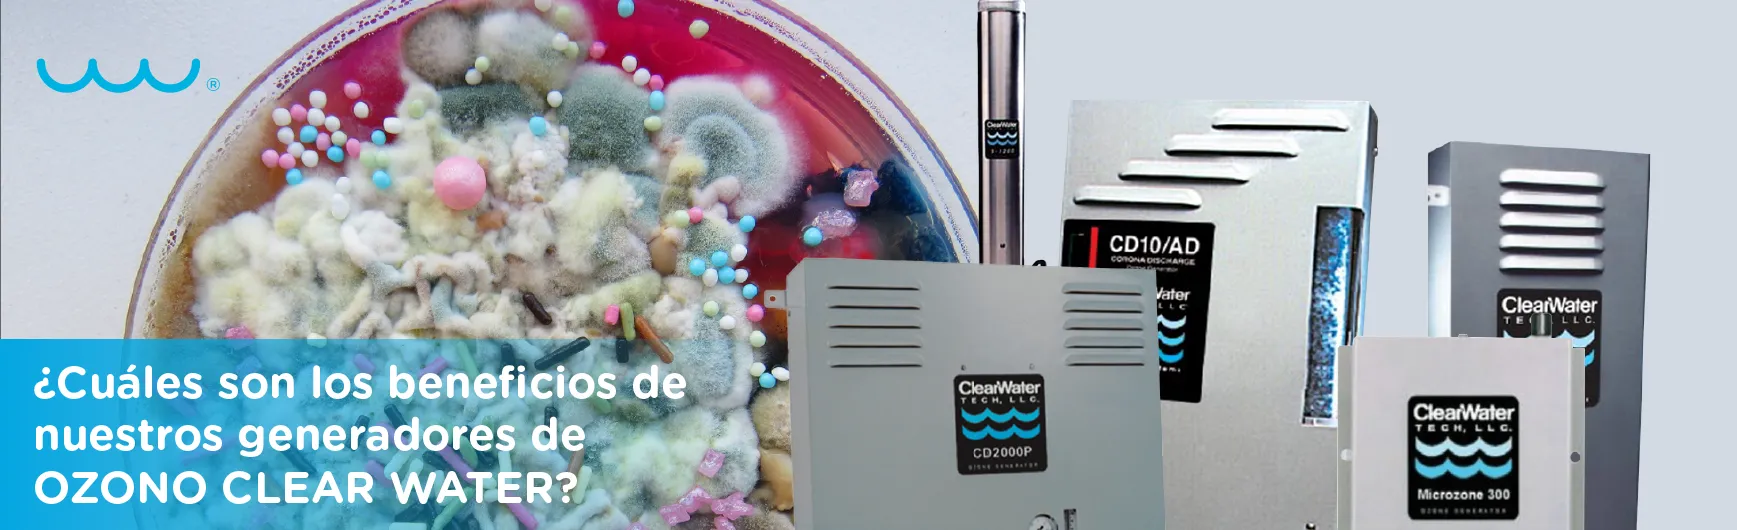
¿Cuáles son los beneficios de nuestros generadores de Ozono Clear Water?

Categorías
-
Filtros de agua 55
-
Línea de laboratorio 29
-
Línea Proceso 14
-
Noticias Water Technologies 1
-
Nuevos Proyectos 16
-
Purificador de agua 102
-
Todos 217
Publicaciones - Todos

¿Qué es una propipeta o pipeteador?
Línea de laboratorio
09 de Junio, 2021

¿Cuáles son las ventajas de un sistema de ósmosis inversa comercial?
Purificador de agua
20 de Mayo, 2021

¿Para qué se utiliza una bomba dosificadora?
Purificador de agua
07 de Mayo, 2021
¿Cuáles son los beneficios de nuestros generadores de Ozono Clear Water?
Purificador de agua
23 de Abril, 2021

Beneficio de la luz ultravioleta germicida en los purificadores de agua.
Purificador de agua
08 de Abril, 2021

¿Sabías que la calidad del agua puede afectar la preparación de tu café?
Filtros de agua
18 de Marzo, 2021

¿Sabías que tener un purificador de agua en casa ayuda al cuidado del medio ambiente?
Purificador de agua
09 de Marzo, 2021

¿Sabes lo importante que es la hidratación en adultos mayores?
Purificador de agua
11 de Febrero, 2021

Una hidratación saludable para los niños.
Filtros de agua
05 de Febrero, 2021

Agua alcalina una mejor hidratación para deportistas.
Filtros de agua
11 de Enero, 2021

¿Sabes cuál es la función de un tanque hidroneumático?
Filtros de agua
08 de Enero, 2021

Top de purificadores de agua ideales para el cuidado de tu salud.
Purificador de agua
18 de Diciembre, 2020

¿Qué tan eficaz es el ozono para desinfectar?
Filtros de agua
02 de Diciembre, 2020

¿Porque la mejor opción esta en las Bombas Centrífuga Iwaki?
Purificador de agua
12 de Noviembre, 2020

¿Tienes idea de que opción es mejor, el purificador de agua o el garrafón?
Purificador de agua
06 de Noviembre, 2020

La presencia del cloro en el agua de tu hogar.
Filtros de agua
29 de Octubre, 2020

Beneficios de instalar un cartucho purificador en tu maquina alimentadora de agua.
Filtros de agua
22 de Octubre, 2020

¿Sabes qué son las aguas residuales y cuál es el origen de donde provienen?
Filtros de agua
15 de Octubre, 2020

¿A qué se debe la presencia del mal sabor del agua?
Filtros de agua
08 de Octubre, 2020

Conoce las bombas neumáticas Iwaki Air
Filtros de agua
01 de Octubre, 2020




























